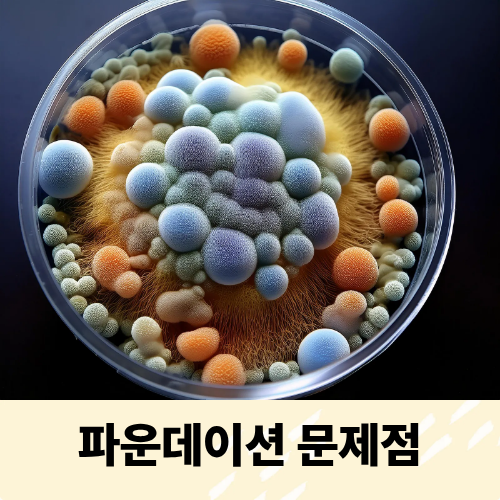
피부건강

여름철 피부 건강을 위해 피해야 할 화장품 5가지





무더운 여름, 피부는 땀과 피지 분비로 인해 민감해지기 쉽습니다. 이러한 시기에 잘못된 화장품 선택은 피부 트러블을 유발할 수 있으므로 주의가 필요합니다. 피부과 전문의들이 여름철 사용을 권장하지 않는 화장품 5가지를 소개합니다.
1. 쿠션 파운데이션
쿠션 파운데이션은 간편한 사용으로 인기를 끌고 있지만, 여름철에는 피지 분비가 증가하여 모공을 막을 수 있습니다. 특히 지성 피부나 여드름이 있는 경우, 쿠션의 반복 사용은 트러블을 악화시킬 수 있습니다. 또한, 퍼프는 세균 번식의 온상이 될 수 있으므로 주 1~2회 세척하거나 자주 교체하는 것이 좋습니다.
2. 톤업 기능 자외선 차단제

톤업 선크림은 피부를 밝게 보이게 하지만, 충분한 양을 바르지 않으면 자외선 차단 효과가 떨어집니다. 특히 여름철 강한 자외선을 효과적으로 차단하기 위해서는 SPF와 PA 지수가 높은 자외선 차단제를 충분히 바르는 것이 중요합니다. 톤업 효과를 원한다면, 자외선 차단제를 먼저 바른 후 톤업 제품을 추가로 사용하는 것이 좋습니다.
3. 고정력 강한 메이크업 픽서

메이크업 픽서는 화장을 오래 유지시켜주지만, 폴리머 성분이 피지와 섞여 모공을 막을 수 있습니다. 또한, 알코올 성분이 포함된 경우 피부를 건조하게 만들고 민감성 피부에는 자극을 줄 수 있습니다. 장기간 사용은 피부 장벽을 약화시킬 수 있으므로 꼭 필요한 경우에만 사용하고, 사용 후에는 꼼꼼한 클렌징이 필요합니다.
4. 프라이머

프라이머는 메이크업의 밀착력과 지속력을 높여주지만, 실리콘 성분이 모공을 막아 여드름 등의 트러블을 유발할 수 있습니다. 특히 여름철 피지 분비가 많아지는 시기에는 프라이머의 사용을 자제하고, 사용 후에는 꼼꼼한 세안으로 잔여물을 제거하는 것이 중요합니다.
5. 클렌징 오일

클렌징 오일은 메이크업과 노폐물을 효과적으로 제거하지만, 여름철에는 피지와 섞여 모공을 막을 수 있습니다. 또한, 오일 성분이 피부에 남아 여드름이나 화이트헤드를 유발할 수 있습니다. 대신, 클렌징 밀크나 로션을 사용하여 부드럽게 메이크업을 제거하고, 진한 화장은 전용 리무버를 사용하는 것이 좋습니다.
여름철에는 피부 상태에 맞는 제품 선택과 올바른 사용법이 중요합니다. 피부과 전문의의 조언을 참고하여 건강한 피부를 유지하시기 바랍니다.